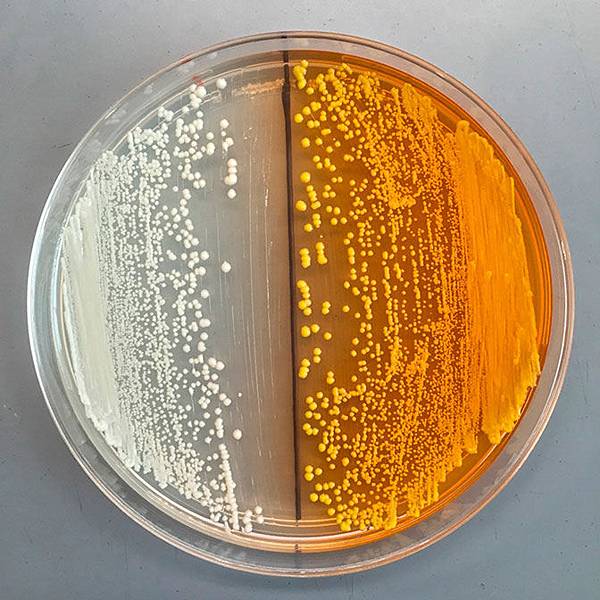

Photo: 溫哥華市區的社區巷道中,人行道旁種的一排罌粟花。
鴉片是屬於化合物 benzylisoquinoline alkaloids (BIAs) 的一種,此類化合物已知的有 2500 種,其中包括嗎啡和 thebaine(為止痛藥 oxycodone 和 hydrocodone 的前導物)之外,還有解痙攣(antispasmodic)、抗生素和抗癌藥物等等。BIAs 的結構複雜很難合成,而且成本也很高,因此醫藥學家一直以來想找出能夠便宜又簡單的製造方法,或是製造出不會上癮和其他副作用的藥物種類,但這並不是件容易的事,因為植物本身生長週期就慢,不過「把 BIA 製成路徑轉進微生物中的話,就能大大減少研發藥物的成本,因為我們可以操作酵母菌的基因,然後快速得到試驗結果。」發表在 Nature Chemical Biology 的作者,目前也是加州柏克萊大學的博士生 William DeLoache 說道 [1, 4]。
這個技術其實之前已經成功用來製造抗瘧疾藥物(antimalarial) artemisinin,但用在製造管制麻醉藥上則是第一回,用酵母菌生產嗎啡的研究從 2009 年時就已經開始,研究主持人為加拿大 Concordia University 的微生物學家 Vincent Martin,也是發表在 PLOS ONE 那邊論文的通訊作者 [1, 3]。跟抗瘧疾藥 artemisinin 製成需要五個反應的過程比起來,嗎啡複雜得多,要到十五個化學反應,研究學者們通常分成兩個部分,第一個部分是把胺基酸 tyrosine 轉換成 S-reticuline(下圖 a),從這裡開始則是第二部分的關鍵分歧點,S-reticuline 可以轉換成嗎啡或 codeine,或是轉換成抗生素或抗癌藥物(下圖 b),如果要轉換成嗎啡,S-reticuline 則需先轉換成 R-reticuline,之後再轉換成 thebaine,最後變成嗎啡 [1, 3]。

圖:在罌粟花中(a)和基改酵母菌中(b) reticuline 產生過程發生的化學反應。(Fossati et al, PLOS ONE 2015)
去年,美國加州史丹福大學的研究主持人 Christina Smolke 發表說他們給酵母菌需要的酵素,使其能完成第二部分的最後步驟:把 thebaine 轉換成嗎啡。而上個月,Martin 則在 PLOS ONE 上發表說他們已改造好酵母菌的基因,使其能完成所有第二部分的反應,把 R-reticuline 轉換成嗎啡。不過至此,第一部分的困難還未克服,把葡萄糖轉(glucose)換成 tyrosine 很簡單,因為天然酵母菌本身就會做此轉換,但是把 tyrsoine 轉換成 S-reticuline 並不容易。2011 年的時候,有日本團隊表示他們能夠在大腸桿菌 E. coli 中完成第一部分,但在酵母菌中轉換的效果不是很好,最大的瓶頸是把 tyrosine 轉換成 L-Dopa [1]。不過呢,柏克萊大學的生物工程學家 John Dueber 和 DeLoache 在做另一個研究計畫時,意外發現有個叫 DOPA dioxygenase 的酵素能把 L-Dopa 轉呈黃色的色素,會讓酵母菌變成黃黃的,於是他們就想到用 DOPA dioxygenase 來找能夠把 tyrosine 轉換成 L-Dopa 的酵素 [1, 4]。接著,他們便和 Martin 的團隊合作,發現甜菜(sugar beets)的一個叫 tyrosine hydroxylase 的酵素能在酵母菌裡把 tyrosine 轉換成 L-Dopa,他們也做了不同的突變種,然後用 DOPA dioxygenase 來測試看哪個突變種的效果最好,能夠產生最多的 L-Dopa [1]。
圖:基因改造過,擁有 DOPA dioxygenase 基因的酵母,產生 L-DOPA 後會把酵母菌染成黃色。(DeLaoche et al, Nature Chemical Biology 2015)
到此為止,待解的化學反應只剩第一部分和第二部分的銜接點,把 S-reticuline 轉換成 L-reticuline 的步驟(下圖),不過這個似乎也成功在即,加拿大卡加利大學 Univ of Calgary 的博士生 Beaudoin 在他的畢業論文摘要中表示,他們發現了一種植物酵素能在酵母菌中把 S-reticuline 轉換成 L-reticuline,如果真的可行的話,研究學者們就能把所有需要的酵素轉進酵母菌當中,測試它是否能完成所有的化學反應,也就是把最初的葡萄糖轉換成最終產物 -- 嗎啡。研究者之一的 Dueber 說,他認為這在未來的兩到三年中可以完成。[1, 5]

圖:基改酵母菌中從葡萄糖(glucose)轉換成嗎啡的過程。(Nature Comment 2015)
基改過的酵母菌可以被人輕易拿來使用,因為酵母菌很好養也容易操作,如果酵母菌能生產十克(10g)的嗎啡,則使用者只要喝 1-2ml 發酵出來的液體便會達到處方籤的標準劑量。要想取代現有的生產系統,用酵母菌生產嗎啡的技術需能夠有效降低成本,目前大量配種繁殖的罌粟花品種,使嗎啡價格在 2001-2007 年之間的降低了 20%,為一公斤美金 $300-500 。目前嗎啡的非法販售管道有二,一是醫師處方的止痛劑(像是 oxycodone 或 hydrocodone)被盜,或是由病人合法取得,但非法賣出;二則是在某些國家,例如阿富汗、緬甸、寮國和墨西哥等國非法種植和製成海洛因,然後由犯罪集團賣出。酵母產出的技術可能因為酵母菌容易隱藏、生長和運送,而使得在北美和歐洲這些需求量高的國家,嗎啡被濫用的情況增高 [2]。因此,在這項研究成果有望之際,Dueber 和 Martin 在一年前便找上 Oye 尋求他的意見,如何使這個研究結果在幫助醫療之餘,不至於被非法濫用。Oye 在《Nature》上給了幾點建議,第一是給基改酵母加入 marker,讓它在實驗室之外的設備難以被培養,例如需要某個特定的養分(nutrient selection marker),或是加入特別的 marker 用以追蹤。二是管制來要基因序列的人,雖然說這種非法販毒集團應該不會這麼搞剛還要序列自己基改。再來是管制培養基改酵母菌的場所,最後則是立法管理 [2]。
**
本魯覺得這真是個聰明的技術,因為光是那十五個化學反應就讓人覺得製造嗎啡是個麻煩的過程,如果全部交給酵母菌來做,我們只要負責讓它長的話,那真的超輕鬆容易的阿,因為酵母菌不難養,而且培養的成本也不高,此法值得拿來用在製造其他難合成又高成本的藥物上阿。
這個研究的最後階段如果成功的話,對於大量生產來用在醫療上應該是大有助益,不過因為它的方便性,要是不小心流出實驗室外,被濫用的可能性也非常高,這也是目前所憂慮的地方。是說反過來想,要是基改酵母真的流出去,培養和製造門檻又低,其實需要的人可以自己養酵母就好了,根本不需要跟販毒集團買阿,這樣販毒集團還有搞頭嗎?因為人人都可自己養酵母,而且只要拿到一點點就可以養出一堆酵母,根本沒賺頭阿,是吧?
PS. 話說可以合法販賣藥用大麻後,溫哥華的大麻店真是如雨後春筍般冒出來阿,方圓五公里內可以有五、六家,溫哥華人有這麼需要大麻嗎?然後,看到這則新聞後,覺得本魯應該要來研究用酵母菌製造大麻,不但可以省水省電省土地,還可以賺 $$,有人要投資嗎?科科~~ XD
**
References
1. RF Service. Researchers closer to engineering yeast that make morphine, spurring worries. Science News Insider (2015)
2. KA Oye, JCH Lawson & T Bubela. Drugs: Regulate 'home-brew' opiates. Nature Comment (2015)
3. E Fossati et al. Synthesis of Morphinan Alkaloids in Saccharomyces cerevisiae. PLOS ONE (2015)
4. WC DeLoache et al. An enzyme-coupled biosensor enables (S)-reticuline production in yeast from glucose. Nature Chemical Biology (2015)
5. GAW Beaudoin. Characterization of Oxidative Enzymes Involved in the Biosynthesis of Benzylisoquinoline Alkaloids in Opium Poppy (Papaver somniferum). PhD Thesis, University of Calgary (2015), unpublished.
沒有留言:
張貼留言
歡迎發表意見